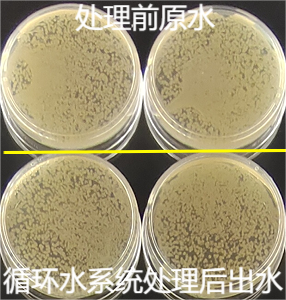
2.png

不能一味推广循环水养殖模式!必须考虑消除尾水中的耐药因子
更新时间:2026-01-15 10:44:47 来源/作者:科学养鱼/周鑫军等
近年来,许多高端水产养殖品种,采用循环水处理系统进行高密度养殖的规模越来越大。
目前,我国常用的水产养殖循环水处理系统采用的处理程序通常是:原水→初级沉淀→过滤→杀菌→氧化曝气→二次沉淀→硝化池→出水(见图1)。也有更简单的处理系统,减少了二次沉淀环节,也未采取沉水植物或漂浮植物吸污措施,这种简易处理系统出水水质相对较差。

图1 水产养殖循环水处理工序
1.循环水系统环境微生物耐药性富集现象普遍且严重
应用循环水系统养殖过程中,养殖对象发生细菌性疾病时,也不可避免地要使用各种内服抗菌药物,当药饵料入水后被养殖对象摄食前,就有药物一定程度地在水中流失,养殖对象摄食药饵后的排泄物中也有一定量的药物残留,这些流失在水环境中的药物都可能使水体中的环境微生物(包括水生动物条件致病菌)产生不同程度的耐药。
2.水产养殖循环水处理系统杀菌能力有限
笔者从多处水产养殖循环水处理系统的进水和排水口取水样,采用BHI培养皿,分别做环境微生物培养,在进水口水样和排水口水样中均可以培养出大量不同形态的菌落,这说明经过循环水系统处理的出水中仍有大量的环境微生物存活(见图2)。
图2 某养殖场循环水系统处理前后可培养的环境微生物菌落
大多数水产养殖循环水处理系统的杀菌效率是有限的,这或许是因为在水产养殖循环水处理过程中硝化池内需要额外添加硝化细菌等微生物的需要,所以不能在杀菌环节后的水中有大量的消毒剂残留;另外,高密度养殖尾水中含有大量有机物,尾水中微生物数量非常多,这些因素导致循环水处理过程中杀菌设备无法彻底杀灭水中的细菌。
3.需高度重视循环水养殖模式环境微生物耐药富集现象
2023年,笔者应邀到某养殖公司进行考察,起因是该养殖场的养殖牛蛙发生细菌性疾病后,12种常用兽用抗生素制剂药物敏感性实验均显示耐药(见图3),而这12种药物中的多数药物,在对其他许多水生动物致病菌的药敏试验中经常显示出敏感。

图3 牛蛙肝脏分离的致病菌对12种兽用抗生素均耐药
我们用移液器从该养殖场循环水系统的进水口(处理前的蛙池排水)和循环水系统的出水口(处理后的蛙池进水)各取50ul水样,均匀涂布在制备好BHI培养皿内,恒温28℃培养24小时,再从2组(4个)培养皿中随机挑选10个形态不同的菌落扩大培养,再使用12种抗生素制剂进行耐药性测试。
结果显示,从循环水系统的进水口(处理前的蛙池排水)水体培养出的菌落中,随机挑选的10株菌落对12种抗生素制剂大多显示出耐药(见图4)。其中8号药物在50mg/L的浓度下对3号菌株显示出抑制作用,12号药物在200mg/L的浓度下对2号、3号、4号、6号菌株显示出抑制作用。

图4 处理前蛙池水中10个菌落对12种抗生素制剂大多显示耐药
从循环水系统的出水口(处理后的蛙池进水)水体培养出的菌落中,随机挑选的10株菌落对12种抗生素制剂均大多显示出耐药(见图5)。其中4号、6号药物在50mg/L的浓度下对1号菌株显示出抑制作用,12号药物在50mg/L的浓度下对3号、4号、5号、8号、9号菌株显示出抑制作用。

图5 处理后蛙池水中10个菌落对12种抗生素制剂大多显示耐药
环境微生物耐药性实验结果分析:说明该养殖场在牛蛙养殖过程中可能使用过含有这些成分的药物;水中的环境微生物(包括可能存在的条件致病菌)都对以往用过的药物产生了不同程度的耐药性;该养殖场的循环水处理系统无法彻底消除微生物耐药因子,由于养殖牛蛙未曾停歇,该养殖场水体中环境微生物的耐药因子在互相传播并长期延续,这也造成了该养殖场的牛蛙感染细菌后用药无效大量死亡。
4.细菌的耐药性相关知识科普
按照是否产生抗生素分类,自然界的微生物可分为:产抗生素类(主要是放线菌和链霉菌),不产抗生素类(大多数细菌属于此类)。这两类微生物常相伴而生,前者由于能够产生抗生素,有杀灭其他细菌的能力而获得生存优势;相反,不产抗生素的细菌则需要获得耐受抗生素的能力,才能存活繁衍。所以,细菌对抗生素耐药是自然界中长期存在的生物现象。从某种意义上讲,人类使用抗菌药物,只是杀灭敏感菌株,留下了耐药菌株。
细菌接触抗菌药物后,通过产生水解酶或钝化酶、改变细胞特性、将药物泵出细胞等方式,不会被抗菌药物杀灭,并代代相传,称为细菌的获得性耐药。
当一段时间未接触到抗菌药物后,细菌也可能会逐渐丢失其耐药性。细菌通过R质粒将自身耐药性水平传播给其他细菌。
5.环境微生物耐药性传导带来的威胁
当水生动物的条件致病菌已经产生多重耐药性,会直接导致水生动物养殖过程中发生细菌性疾病后,很难找到有效药物,甚至无药可治,对养殖业带来巨大的损失。
养殖尾水中微生物对多种使用过的抗菌药物耐药,并可能传播给人类的致病菌,最终威胁人类健康!
我们不能一味推广循环水养殖模式,而对采用循环水系统养殖一段时间后,养殖对象普遍多发生细菌性疾病、且难以治疗的状况视而不见!
应用水产养殖循环水处理系统,必须考虑如何消除水产养殖尾水中的耐药因子!
养殖环节科学用药,可以一定程度上减少细菌耐药性的产生!养殖对象发生细菌性疾病初期,先通过药敏试验找到有效药物,确定准确的使用剂量,再足量足疗程科学精准地使用有效药物,为养殖户节约用药成本,实现减抗目标!
友情链接
【政府部门】: 农业农村部 | 广东省农业农村厅 | 全国水产技术推广站
【科研院所】: 华南农业大学 | 中山大学 | 广东海洋大学 | 仲恺农业工程学院 | 上海海洋大学 | 中国水产科学研究院珠江水产研究所 | 中国水产科学研究院南海水产研究所
咨询服务:020-34466381 | 合作服务:18620920190 | 会员服务: 020-34466381
地 址:广州市南沙区东涌镇市南路4号段广东海洋与水产高科技园4号楼 邮编:511453
Copyright 2006-2019广东省水生动物卫生协会版权所有
返回顶部